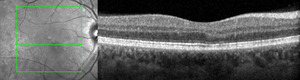

INTRODUCTION
Acute macular neuroretinopathy is a nonprogressive, outer retinal disease first identified by Bos and Deutman in 1975.1 This disease commonly affects White women in the third decade of life who are presenting with visual disturbances, including paracentral scotomas and decreased vision.2 Several risk factors have been associated with this condition, including recent viral illness and oral contraceptive medications.2–4 There have also been case series correlating severe acute respiratory syndrome coronavirus 2 (SARS-CoV-2) infection and coronavirus disease 2019 (COVID-19) vaccination with acute macular neuroretinopathy diagnosis.3–8 Although the disease pathophysiology is uncertain, outer retinal and choroidal vascular ischemia have been implicated as 2 possible sites of disease origin.9,10 Multimodal retinal imaging including near-infrared reflectance and optical coherence tomography aid in differentiating among myriad outer retinal and choroidal conditions. Patients with this disease often suffer irreversible outer retinal changes that may result in persistent scotomas.2,11 There is no established treatment for this condition. No identifiable health information was included in this case report.
CASE REPORT
Initial Encounter
A 36-year-old White woman presented as a new patient with complaints of a blind spot in her right eye. Her symptoms started suddenly 4 months prior to examination yet remained stable regarding the size and location of the visual field defect. She localized the defect superotemporal to fixation in the right eye. She denied having recent ocular trauma or personal medical changes related to symptom onset. No other ocular concerns were expressed during the initial case history.
Her personal ocular history was notable for right congenital cranial nerve IV palsy and strabismus operation performed on the right eye in 2005. Additionally, she was seen twice by a local optometrist the day and month after symptom onset. Without provider access to advanced imaging, she was advised to seek care at a local academic medical center for further ophthalmic evaluation.
Her personal medical history was remarkable only for asthma. However, she measured her blood pressure daily at her primary care provider’s recommendation with self-reported readings consistently around 130/80 mm Hg. Her medication list included an albuterol inhaler (RPK Pharmaceuticals, Inc.), loratadine (Bayer HealthCare LLC), montelukast (Organon), and oral norethindrone-estradiol-iron (Lupin Pharmaceuticals, Inc.). She denied having medication allergies or past use of tobacco products.
Her family medical history was unremarkable. Her family ocular history included glaucoma for her maternal grandfather.
Uncorrected distance visual acuities were 20/20-1 in the right eye and 20/25-3 in the left eye. Pupillary evaluation was equally round and reactive to light without an afferent pupillary defect in either eye. Extensive evaluation of extraocular muscles revealed underaction of the superior oblique muscle and overaction of the inferior oblique muscle in the right eye, whereas all muscles were full and unrestricted in the left eye. Confrontation fields were full in both eyes. Tonometry measured 12 mm Hg for both eyes.
Anterior segment examination was unremarkable. Dilated vitreous and posterior segment evaluation was also unremarkable except for a small, faint, ovoid lesion inferonasal to the fovea in the right eye.
Fundus photography (California Optomap, Optos plc, Dunfermline) captured an image of the faint lesion in the right eye, whereas fundus autofluorescence imaging showed an area of subtle hyperautofluorescence (Figure 1). Optical coherence tomography (Spectralis, Heidelberg Engineering) imaging of the macula with near-infrared reflectance revealed a well-defined, hyporeflective ovoid lesion pointing toward the fovea in the right eye (Figure 2). B-scan images through the lesion demonstrated subtle outer plexiform layer hyperreflectivity and thickening, outer nuclear layer thinning, and attenuation of the ellipsoid and interdigitation zones (Figure 2).
The patient was diagnosed with acute macular neuroretinopathy of the right eye given her clinical finding, classic demographics, and oral contraceptive medication risk factor. No treatment was initiated. She was instructed to return in 1 month for follow-up examination.
Follow-up Encounter #1
The patient presented 1 month later with symptoms unchanged from her initial examination. No other ocular concerns were reported. Based on her diagnosis of acute macular neuroretinopathy, additional case history questions were asked to elucidate an underlying etiology.2–4
-
Viral illness or vaccination prior to onset? Type of illness or vaccine?
Yes; Hepatitis A Vaccine (HAVRIX, GlaxoSmithKline Biologicals, Rixensart, Belgium) and Typhoid Vaccine Live Oral Ty21a (VIVOTIF, Berna Biotech, Ltd., Bern, Switzerland) administered 33 days prior to symptom onset.
-
When was oral contraception originally initiated? Any changes to this medication prior to onset?
Initiated at age 19. No recent medication changes.
-
Exposure to epinephrine or ephedrine prior to onset?
No.
-
Antecedent, nonocular trauma prior to onset?
No.
-
Systemic shock (ex. Toxic Shock Syndrome) prior to onset?
No.
-
Caffeine consumption prior to onset?
Little to no caffeine consumption.
She presented with spectacles, and corrected distance visual acuities were 20/20 in the right eye and 20/20-1 in the left eye. Lensometry was right eye -0.25 - 0.25 × 090 and left eye -0.50 - 1.25 × 020. Entrance testing remained unchanged from the initial presentation. Tonometry measured 11 mm Hg in the right eye and 13 mm Hg in the left eye. The patient performed an Amsler grid test prior to dilation, demonstrating a superotemporal, paracentral scotoma relative to fixation in the right eye. Standard automated perimetry was unavailable and not performed.
Anterior segment examination remained unremarkable. Dilated examination remained significant only for the faint macular lesion in the right eye.
Optical coherence tomography (Cirrus, Zeiss) imaging of the macula with near-infrared reflectance was performed using a separate imaging platform because of equipment availability. En face images identified the macular lesion within the inner segment/outer segment–ellipsoid zone slab, whereas B-scan images through the macular lesion showed stable structural findings compared with the initial visit (Figure 3).
Optical coherence tomography angiography (RTVue XR Avanti, Optovue Inc.) with 6 × 6-mm angiograms was acquired. System software restricted quantified analysis of the vessel density below the superficial retinal vascular slab. Qualitative analysis of the vascular slabs in the right eye showed no appreciable decrease in vessel density within the superficial, deep, or choriocapillaris slabs (Figure 4). The outer retina slab is inherently avascular and revealed an area of hyporeflectivity from projection artifact (Figure 4). Standard fluorescein and indocyanine green angiography were not ordered because of limited diagnostic utility for acute macular neuroretinopathy.
The patient was informed that her examination findings remained stable in the right eye. No treatment was initiated. She was instructed to return in 6 months for follow-up examination; however, she was scheduled at 4 months because of conflicting travel plans.
Follow-up Encounter #2
The patient presented 4 months later with stable visual symptoms regarding the scotoma in her right eye. However, she noted occasional floaters in both eyes (right greater than left), and these were likely due to increased vigilance from her scotoma. She denied having any flashes of light or other changes in vision. Lastly, she reported several recent vaccinations including her second hepatitis A vaccine without new or worsened visual symptoms.
Spectacle-corrected distance visual acuities were 20/20 in the right and left eyes. Lensometry measurements and entrance testing were unchanged from her first follow-up visit. Tonometry measured 11 mm Hg in the right eye and 12 mm Hg in the left eye.
Swedish Interactive Threshold Algorithm Standard automated perimetry (Humphrey, Zeiss) was performed undilated for both eyes using a Central 10-2 Threshold Test pattern. Right eye testing revealed a relative, superotemporal paracentral scotoma corresponding to the inferonasal location of the macular lesion (Figure 5).
Anterior segment examination remained unremarkable. Extended ophthalmoscopy without scleral depression examination revealed mild syneresis without any pigmented or inflammatory cells in both eyes. Retinal examination remained significant only for the faint macular lesion in the right eye; there were no holes, tears, or breaks in either eye.
Optical coherence tomography (Cirrus, Zeiss) of the macula demonstrated stable structural findings compared with those from the patient’s previous 2 visits (Figure 6).
The patient was informed that her examination findings remained stable in the right eye. No treatment was initiated. Management included extending observation to yearly visits. She was instructed to return sooner with new or worsening visual symptoms.
DISCUSSION
Acute macular neuroretinopathy is a nonprogressive, retinal condition first described by Bos and Deutman in 1975 when they identified peculiar, wedge-shaped macular lesions pointing toward the fovea in 4 female patients with paracentral scotomas.1 In 2016, Bhavsar et al reviewed 156 eyes from 101 case reports spanning from 1975 through 2014, leading many clinicians to view it as a rare ocular manifestation.2 Recently, however, there has been an increase in published cases of acute macular neuroretinopathy likely from improved disease awareness, access to high-quality optical coherence tomography imaging, and possible associations with SARS-CoV-2 infection and COVID-19 vaccination.3–5
Classic demographics for this condition include women presenting in the third decade of life.2–6 The average age at presentation is 29.5 years old, and non-Latino White patients account for 80% of cases.2 However, recent case series have commented on neither race nor ethnicity despite several publications based out of China.4–8
Scotomas are the most common presenting visual complaint, and initial visual acuity is often 20/40 or better.2,6 Bilateral presentation accounts for 54.4% of patient cases but is reported as high as 100% after SARS-CoV-2 infection.2,4,6 At final examination, persistent scotomas remain in 53.2% of patients.2
The pathophysiology for acute macular neuroretinopathy is not fully understood but focal ischemia in the deep capillary plexus or choriocapillaris have been implicated in reviews involving optical coherence tomography imaging including angiography.2,9,10 Early-onset spectral domain optical coherence tomography changes within the outer plexiform and nuclear layers suggest ischemia of the deep capillary plexus.9 Conversely, optical coherence tomography angiography demonstrated reduced intralesional vessel density within the deep capillary plexus and choriocapillaris, but only significant decrease in the global vessel density was noted within the choriocapillaris.10 Further localization of these lesions within the ellipsoid zone with en face imaging suggests the photoreceptors are the primary target, which are most supported by choriocapillaris blood supply.10 Ultimately, disagreement remains about the site of disease origin.
The exact etiology for acute macular neuroretinopathy has not been determined, but multiple associated risk factors have been identified. Infection or febrile illness and oral contraceptives are among the most reported risk factors.2 Less common risk factors include epinephrine/ephedrine, nonocular trauma, systemic shock, and caffeine consumption.2 Recent case series have linked acute macular neuroretinopathy diagnosis to SARS-CoV-2 infection and COVID-19 vaccination.3–8 However, there have been no published cases associating hepatitis A or live oral typhoid vaccinations with acute macular neuroretinopathy diagnosis.
Febrile illness, in particular SARS-CoV-2, has demonstrated severe inflammation, hypercoagulability, and possible thromboembolism.12,13 SARS-CoV-2 infection may also induce endothelial cell damage causing microvascular disease within the deep capillary plexus, leading to acute macular neuroretinopathy.14 Liu et al reviewed 14 patients diagnosed with acute macular neuroretinopathy that exhibited acute vision loss and positive polymerase chain reaction test results for SARS-CoV-2 within a 1-week period.4 The average time from initial fever to visual symptoms was 3 days and ranged 1 to 5 days.4 The patient in this report denied having any known febrile illnesses prior to symptom onset. However, subclinical SARS-CoV-2 infection cannot be completely ruled out.
Oral contraceptive medications are associated with thrombotic events, and higher concentrations of estrogen may enhance this risk.15 These medications have been linked to retinal arterial and venous occlusions, in addition to acute macular neuroretinopathy.1–3,16–20 Several acute macular neuroretinopathy cases identified combined oral contraception and febrile illness or vaccination risk factors.1,3,18–20 No established timeline exists from initiation of oral contraceptives to visual symptom onset, and no recommendation exists for discontinuing these medications after acute macular neuroretinopathy diagnosis. The patient in this case reported taking oral contraception for 17 years, indicating an increased risk for perceived hypercoagulability.
There has been an uptick in acute macular neuroretinopathy cases after COVID-19 vaccinations. Surveillance reports for various COVID-19 vaccines cite minor side effects including fatigue, muscle pain, headache, and chills, and rare instances of thrombocytopenia have occurred.21,22 Fekri et al reviewed 21 cases of acute macular neuroretinopathy after COVID-19 vaccination with symptom onset averaging 8 days and ranging from 1 to 21 days after vaccination.3 COVID-19 vaccination may lead to acute macular neuroretinopathy through an inflammatory cascade causing microvascular dysfunction within the deep capillary plexus.20 This effect may be exacerbated with oral contraception due to preexisting thrombophilia.20
Prior to the SARS-CoV-2 outbreak, acute macular neuroretinopathy was rarely reported after routine vaccination. Few case reports are linked to influenza vaccines with symptom onset ranging from 7 to 9 days after vaccination.23–25 Retinal vasculitis secondary to vaccination is also infrequently cited. One case documented retinal vasculitis 1 month after swine flu vaccination, whereas a second case report occurred 2 months after administration of diphtheria, tetanus and polio, and hepatitis A and typhoid vaccinations.26
The US Food and Drug Administration has 2 approved hepatitis A vaccines. Hepatitis A Vaccine (HAVRIX, GlaxoSmithKline Biologicals) received initial US approval in 1995 for routine vaccination of persons 12 months and older against hepatitis A disease with a 2-dose series.27 Clinical trials included approximately 37 000 individuals with injection-site pain, headache, and fever as the most common adverse effects, whereas rare postmarketing occurrences include thrombocytopenia and vasculitis.27
The US Food and Drug Administration has 1 approved live oral typhoid vaccine. Typhoid Vaccine Live Oral Ty21a received FDA approval in 1989 for adults and children over 6 years old with specific indications for travelers or individuals with possible exposure to Salmonella typhi as well as for microbiology laboratorians.28,29 Routine vaccination is not recommended.28 Four oral capsules are taken every 2 days and completed 1 week before exposure.28 Over 150 million doses were marketed worldwide through 2013, with infrequent, mild adverse effects including diarrhea, abdominal pain, nausea, and fever.28
The patient’s vaccination records confirm hepatitis A and live oral typhoid vaccines 33 days prior to symptom onset, which is atypical for both COVID-19 and influenza vaccination timelines. It is plausible her seroconversion took 33 days as 1 large study demonstrated 88% seroconversion for hepatitis A vaccine through 2 weeks,30 whereas no specific timeline exists for typhoid vaccine live oral Ty21a. It is also not clear when she ingested her fourth typhoid vaccine capsule. Additionally, the overlap in adverse reaction profiles for hepatitis A, typhoid, and COVID-19 vaccines indicates routine vaccines may potentiate a significant immune system response. It is reasonable that her recent vaccinations and possible hypercoagulability from oral contraception had a cumulative vasculopathic effect resulting in acute macular neuroretinopathy.
Acute macular neuroretinopathy can be challenging to diagnose without multimodal imaging. Fundoscopy or fundus photography may reveal reddish-brown lesions in a wedge, petaloid, oval, or teardrop shape.2 Perimetric testing is more sensitive as 73.7% of patients exhibit paracentral scotomas matching the size and location of the lesions.2 Fundus autofluorescence is often unremarkable, with few case reports of either subtle hyperautofluorescence or hypoautofluorescence.2,5,6,19,31 A single case report of hyperautofluorescence was documented 3 weeks after acute vision changes.31 Interestingly, this patient exhibited subtle hyperautofluorescence at 4 months after symptom onset, which has not been reported at this interval. Fluorescein angiography and indocyanine green angiography are typically unremarkable.2,6
Multimodal imaging of the retina with combined near-infrared reflectance and spectral domain optical coherence tomography is most sensitive in detecting acute macular neuroretinopathy. Near-infrared reflectance uses infrared light between 804 and 895 nm to image the outer retina, retinal pigment epithelium, and choroid.32 These wavelengths are closer to the visible light spectrum compared with infrared light, penetrate deep into the ocular tissues, bypass media opacities, and exhibit high reflectance from the fundus for enhanced disease detection.32 This imaging modality reveals hyporeflective, well-demarcated lesions that are more discernible than fundoscopy and have been documented up to 6 years after initial diagnosis.2,19 This patient exhibited a distinct, hyporeflective retinal lesion with near-infrared reflectance at 4, 5, and 9 months from initial symptom onset. Spectral domain optical coherence tomography has demonstrated outer plexiform and nuclear layer hyperreflectivity as early as 1 day after symptom onset.9 Most cases using spectral domain optical coherence tomography imaging detected outer retinal changes, which may include ellipsoid zone disruption, outer nuclear hyperreflectivity, and outer plexiform hyperreflectivity.2,7–9 Persistent retinal changes often consist of outer nuclear thinning and interdigitation zone disruption, which have been documented up to 16 months after initial symptom onset.7–9 Outer plexiform thickening has also been reported up to 173 days from the initial visit, whereas hyperreflective change may improve.7,8 Similarly, this patient displayed subtle outer plexiform layer hyperreflectivity and thickening, outer nuclear layer thinning, and attenuation of the ellipsoid and interdigitation zones through 9 months from initial symptom onset. Notably, the outer plexiform layer hyperreflectivity that persisted through 9 months has not previously been reported at this duration.
Optical coherence tomography angiography is a noninvasive imaging technique used to map retinal and choroidal vascular networks via red blood cell motion detection. Recent reviews using this imaging modality have enhanced our acute macular neuroretinopathy pathophysiology understanding.6,10,33 Focal flow voids may be observed within the deep capillary plexus and choriocapillaris corresponding to acute macular neuroretinopathy lesions.6,7,10,33 Decreases in global vessel density have been identified only within the choriocapillaris.10 This patient demonstrated no discernible qualitative changes in the superficial, deep, or choriocapillaris vascular slabs, albeit with a lower resolution 6 × 6-mm angiogram acquired 5 months after initial symptoms onset.
Treatment and Management
No proven treatment is available for acute macular neuroretinopathy. Few case reports cite oral prednisone treatment for acute macular neuroretinopathy; however, patients maintained persistent outer retinal disruption on optical coherence tomography and subjective scotomas.5 Consequently, management for this nonprogressive disease includes monitoring and minimizing vasculopathic risk factors.2,19 Lastly, patients should be counseled on possible recurrence.19
CONCLUSION
A complete understanding of acute macular neuroretinopathy etiology and pathophysiology evades clinicians despite advances in retinal imaging with improved diagnostic accuracy. Traditional risk factors include febrile illness and oral contraception, but the SARS-CoV-2 outbreak and subsequent COVID-19 vaccines have garnered a noticeable increase in acute macular neuroretinopathy cases. Vaccination presents a plausible disease mechanism of widespread inflammation resulting in small vessel ischemia within the retinal or choroidal circulatory systems. Routine vaccines, including hepatitis A and live oral typhoid vaccines, may also potentiate an immune response with unintended side effects. This case report chronicles clinical findings of acute macular neuroretinopathy 9 months after symptom onset, and it is the first case report to identify 2 novel risk factors in the hepatitis A and live oral typhoid vaccines. To advance our understanding of acute macular neuroretinopathy, clinicians should be able to accurately diagnose this disease and conduct complete patient interviews, and they are encouraged to publish their clinical findings.
ACKNOWLEDGMENTS
The author would like to acknowledge Drs Bryce St. Clair, OD, MPH, and Amanda Crum, OD, MS (Johns Hopkins Wilmer Eye Institute) for their contributions to this case report.